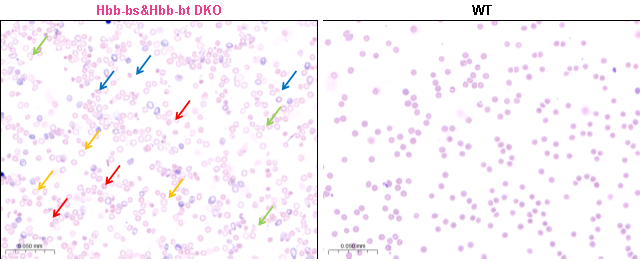
产品细节图片5

相关产品推荐更多 >
万千商家帮你免费找货
0 人在求购买到急需产品
- 详细信息
- 询价记录
- 文献和实验
- 技术资料
- 服务名称:
全身性基因敲除
- 提供商:
赛业生物
Hbb-bs&Hbb-bt DKO小鼠
产品编号:C001508
品系全称:C57BL/6JCya-Hbb-bsem1Hbb-btem1/Cya
品系背景:C57BL/6JCya
传代建议:杂合与野生型互配
品系描述
β地中海贫血(β-thalassemia)是一种由血红蛋白β链(β-globin)合成减少或缺失引起的遗传性血液疾病,是WHO关注的全球社会公共问题之一 [1]。血红蛋白(Hemoglobin, Hb)是红细胞中负责将氧气输送到全身的蛋白质,其结构主要由两个α-globin亚基和两个β-globin亚基组成。每个亚基都包含一个血红蛋白分子中心的血红素(Heme)分子,血红素可结合一个铁离子,使血红蛋白具有携氧的能力。在正常成年人体内,β-globin链由HBB基因编码。两条β-globin链与两条α-globin链(由HBA1基因或HBA2基因编码)构成的成人血红蛋白(HbA)约占总血红蛋白的97% [2]。β地中海贫血患者HBB基因突变造成β-globin链合成减少或缺失,导致血红蛋白水平较低并引起红细胞生成障碍、红细胞过早破坏和贫血等症状。由导致β-globin链生成完全缺失的突变造成的地中海贫血称为β0地中海贫血,而由β-globin链生成部分受抑制的突变导致的则称为β+地中海贫血 [3]。重型β地中海贫血患者携带β0或β+地中海贫血纯合突变或β0与β+地中海贫血双重杂合突变,β-globin链生成完全或几乎完全缺失,以致含有β-globin链的HbA合成减少或消失。β-globin链的缺失造成α-globin链与非α-globin链合成比例不平衡,导致α-globin链相对过剩并在红细胞内形成包涵体,导致红细胞膜的氧化损伤,造成红细胞破坏及骨髓无效造血。轻型β地中海贫血患者携带β0或β+地中海贫血杂合突变,β-globin链合成轻度减少,其病理症状较轻。中间型β地中海贫血患者携带某些β+地中海贫血双重杂合突变和某些异型地中海贫血纯合突变,或两种不同变异型珠蛋白生成障碍性贫血突变的双重杂合状态,其病理生理改变介于重型和轻型之间 [4]。
C57BL/6Cya小鼠存在Hbb-bs和Hbb-bt两个高度相似的成年β-globin蛋白编码基因,这两个基因位于小鼠7号染色体上的相邻位置且都包含3个外显子 [5-6]。Hbb-bs&Hbb-bt DKO小鼠是利用基因编辑技术同时敲除C57BL/6JCya小鼠Hbb-bs基因和Hbb-bt基因所构建的β地中海贫血疾病模型。该模型纯合致死,杂合小鼠呈现血红蛋白含量、红细胞计数、红细胞压积、平均红细胞血红蛋白浓度、红细胞分布宽度、血小板数、脾脏大小和红细胞形态等指标异常的严重地中海贫血典型特征并具有生育能力。因此,杂合Hbb-bs&Hbb-bt DKO小鼠可用于与β地中海贫血相关的研究。
构建方式
利用基因敲除技术同时敲除小鼠的Hbb-bs基因和Hbb-bt基因。

研究应用
该模型可用于β地中海贫血的机制研究以及治疗药物/疗法的研发、筛选和相关的药效评估。
验证数据
(1) 生长曲线

图1. 杂合Hbb-bs&Hbb-bt DKO小鼠和野生型(WT)小鼠的体重变化曲线。雌性和雄性杂合Hbb-bs&Hbb-bt DKO小鼠均呈现和野生型小鼠较为一致的生长状况。
(2) 生存曲线

图2. 杂合Hbb-bs&Hbb-bt DKO小鼠和野生型(WT)小鼠的生存曲线(♂n=9,♀n=8)。雄性杂合Hbb-bs&Hbb-bt DKO小鼠在第13周开始出现死亡情况,雌性杂合Hbb-bs&Hbb-bt DKO小鼠在第15周开始出现死亡情况。
(3) 血常规检测

图3. 14周龄雄性杂合Hbb-bs&Hbb-bt DKO小鼠和野生型(WT)小鼠血常规检测。血常规检测结果表明,与野生型小鼠相比,杂合Hbb-bs&Hbb-bt DKO小鼠的红细胞计数(RBC)、血红蛋白含量(HGB)和红细胞压积(HCT)显著下降,平均红细胞血红蛋白浓度(MCHC)略有下降,而红细胞分布宽度(RDW)和血小板计数(PLT)明显上升。这些参数变化与相似基因突变类型导致的β地中海贫血临床表型相似。
(4) 血涂片分析
图4. 14周龄雄性杂合Hbb-bs&Hbb-bt DKO小鼠和野生型小鼠(WT)血涂片检测分析。血涂片分析结果显示杂合Hbb-bs&Hbb-bt DKO小鼠有核细胞数占比增加,红细胞中央浅染区扩大且出现较多异形、碎片红细胞和有核红细胞。其外周血中存在靶形红细胞(黄色箭头)、棘形状红细胞(红色箭头)、泪滴状红细胞(绿色箭头)和破碎状红细胞(蓝色箭头)等多种异常形态红细胞。野生型小鼠红细胞形态结构完整,呈现双凹圆盘状且未见明显异常。
参考文献
[1] Galanello R, Origa R. Beta-thalassemia. Orphanet J Rare Dis. 2010 May 21;5:11.
[2] Hardison RC. Evolution of hemoglobin and its genes. Cold Spring Harb Perspect Med. 2012 Dec 1;2(12):a011627.
[3] Thein SL. Molecular basis of β thalassemia and potential therapeutic targets. Blood Cells Mol Dis. 2018 May;70:54-65.
[4] Origa R. β-Thalassemia. Genet Med. 2017 Jun;19(6):609-619.
[5] Zhang F, Zhang B, Wang Y, Jiang R, Liu J, Wei Y, Gao X, Zhu Y, Wang X, Sun M, Kang J, Liu Y, You G, Wei D, Xin J, Bao J, Wang M, Gu Y, Wang Z, Ye J, Guo S, Huang H, Sun Q. An extra-erythrocyte role of haemoglobin body in chondrocyte hypoxia adaption. Nature. 2023 Oct;622(7984):834-841.
[6] Trimborn T, Gribnau J, Grosveld F, Fraser P. Mechanisms of developmental control of transcription in the murine alpha- and beta-globin loci. Genes Dev. 1999 Jan 1;13(1):112-24.
发布时间:2024-09-29
- Confidential -
风险提示:丁香通仅作为第三方平台,为商家信息发布提供平台空间。用户咨询产品时请注意保护个人信息及财产安全,合理判断,谨慎选购商品,商家和用户对交易行为负责。对于医疗器械类产品,请先查证核实企业经营资质和医疗器械产品注册证情况。
- 作者
- 内容
- 询问日期
 文献和实验
文献和实验摘要 生物样本往往是非单一细胞的混合物,如原代分离的细胞样本和许多培养的细胞样本都是由不同种类或不同功能的细胞组成。而对于样本中不同细胞亚群的区分和定量恰恰是很多研究中的关键一环。这些混合在一起的不同细胞通常是使用流式细胞仪和荧光标记的细胞类型特异性抗体来进行区分的。值得注意的是,许多细胞的类型和生理状态的鉴定不仅仅可以通过蛋白表达的变化来鉴别,也可以根据细胞大小的变化来区分。 对疾病模型小鼠的脾脏细胞进行检测,可以监测小鼠体内的免疫系统的变化,但脾脏细胞样本是比较
之一。在此期间发现动物有病者,应更换别的批次动物。也有的是实验动物体重尚达不到实验所要求的大小,这种情况下可适当延长适应性喂养的时间。 第四、实验动物的饲料。 饲料是一个很重要的方面。我们要了解常用实验动物基本的饲料组成。同时,也要了解造一些疾病模型所需的饲料组份(如:高脂模型,缺铁性贫血模型等)。因此,下面分普通饲料和特殊饲料两部分来讲。A 普通饲料 以常用的实验动物为例,我们来讨论一下它们饲料的组成。 一是小鼠、大鼠的饲料。以玉米、大豆、麸皮、鱼粉为主,辅以复合维生素、骨粉、微量
得多,而且病变部位并不出现在主动脉弓。病理表现为纤维组织和平滑肌增生为主,可有大量泡沫样细胞形成斑块,这与人类的情况差距较大。因此要求研究者懂得,各种动物所需的诱发剂量、宿主年龄、性别和遗传性状等对实验的影响,以及动物疾病在组织学、生化学、病理学等方面与人类疾病之间的差异。要避免选用与人类对应器官相似性很小的动物疾病作为模型材料。为了增加所复制动物疾病模型与人类疾病的相似性,应尽量选用各种敏感动物与人类疾病相应的动物模型,可参考表9-1。 表9-1 各种敏感动物与人类相似的疾病模型
 技术资料
技术资料暂无技术资料 索取技术资料







